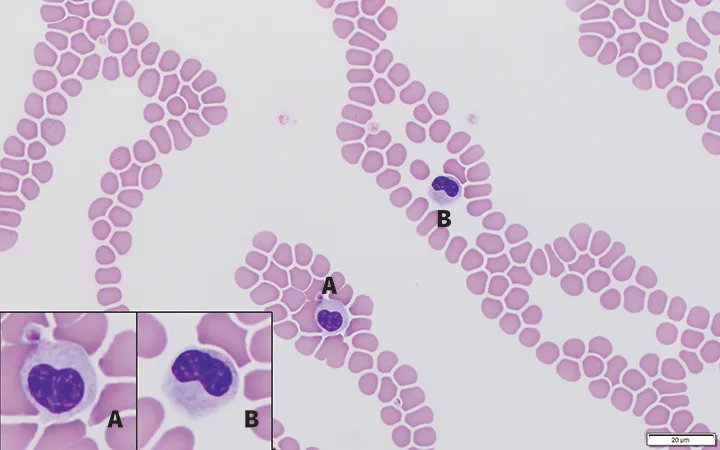
selected slide image

Apparent Degenerative Left Shift in an Australian Shepherd Dog
Emily Davis, DVM, Kansas State University
Lisa M. Pohlman, DVM, MS, DACVP, Kansas State University

A 4-year-old, 32-lb (14.5-kg) neutered male Australian shepherd dog was missing for 4 days after running away while on a walk in a wooded area after hearing a gunshot. Once found, his owner brought him to the clinic.
Physical Examination
On physical examination, the dog was bright, alert, and responsive. BCS was 2/5. Findings were within normal limits, except for an ≈3-inch by 2-inch lesion consistent with acute moist dermatitis on the right dorsal shoulder.
The lesion was clipped and cleaned with 2% chlorhexidine solution, and the owner was instructed to clean it twice daily until the lesion resolved.
Although systemic illness was not suspected, CBC and serum chemistry profile were performed. No significant abnormalities were identified on chemistry, but the in-clinic blood film review revealed an apparent degenerative left shift, which is defined as the occurrence of more young neutrophilic granulocytes (usually bands, but may include metamyelocytes and myelocytes) in circulation than mature (segmented) neutrophils. Neutropenia is common in patients with degenerative left shift, but the neutrophil concentration may be within the reference interval or, less commonly, the neutrophil concentration may be increased.1 As a result of these findings, an EDTA blood sample was submitted to a clinical pathologist for repeat CBC and blood film evaluation (Table 1). Morphologic assessment from the blood film revealed that all neutrophils and eosinophils on the smear had hyposegmented nuclei with mature, clumped chromatin (Figures 1-4). No evidence of toxic change was seen.
SELECTED VALUES & BLOOD FILM EVALUATION FROM REPEAT CBC DATA
DIAGNOSIS:
PELGER-HUËT ANOMALY
Diagnosis
Pelger-Huët anomaly was diagnosed based on morphology of the granulocytes, in which the nuclei of all neutrophils and eosinophils on the blood smear exhibited hyposegmentation with characteristic mature chromatin. Absence of toxic change in the neutrophil line, consideration of the patient’s breed, and absence of apparent systemic illness supported the diagnosis.
Treatment & Management
Treatment is not required for Pelger-Huët anomaly.
Discussion
Pelger-Huët anomaly is an inherited, benign condition characterized by hyposegmentation of granulocytes (ie, neutrophils, eosinophils, basophils) that has been reported in dogs, cats, horses, rabbits, mice, and humans. Pelger-Huët anomaly has been identified in purebred and crossbreed dogs.1-6 Australian shepherd dogs, Australian cattle dogs, basenjis, border collies, German shepherd dogs, English foxhounds, and American foxhounds are overrepresented.3
The defining feature of Pelger-Huët anomaly is hyposegmentation of mature granulocytes. Nuclear shapes can be round, heart (Figure 1), oval (Figure 2), reniform (Figure 1), peanut (Figure 3), band (Figure 3), or bilobed; nuclei concurrently exhibit mature, coarse chromatin.2 Neutrophils from affected patients can be confused with immature forms (eg, band neutrophils, metamyelocytes, myelocytes), resulting in inappropriate interpretation of a left shift and confounding appropriate identification of the condition.3 Pelger-Huët neutrophils should be referred to as such and not misclassified as bands, metamyelocytes, or myelocytes, as these imply the presence of inflammation.1 Identification of hyposegmented eosinophils and basophils with clumped chromatin (Figure 4) can also help confirm suspicion of Pelger-Huët anomaly. No basophils were seen on the blood film in this case.
This mutation is an autosomal dominant trait with incomplete penetrance and has been demonstrated to be caused by the gene encoding the lamin-B receptor in humans and mice.2,3,7 In addition to granulocytes, megakaryocytes are also affected, suggesting that a stem cell defect can result in failure to lobulate.2
Heterozygous patients do not have any clinical signs of a disease process,3 making the heterozygous form of the Pelger-Huët anomaly an incidental finding during examination of a blood smear.2 The homozygous phenotype has not been reported in adult dogs, suggesting it is lethal in utero or these dogs die shortly after birth,3 similar to homozygous rabbits and cats, which have both been reported to exhibit skeletal deformities.8
The frequency of this condition is unknown in many veterinary species. One study demonstrated the Pelger-Huët anomaly has an incidence of 9.8% in Australian shepherd dogs, but these data may have a geographic bias (West Coast of the United States) and may be influenced by intensive inbreeding and line breeding.3 Further studies are required to assess the incidence of this anomaly in other dog breeds and veterinary species.
FIGURE 1
Feathered edge of a blood film from an Australian shepherd dog with inherited Pelger-Huët anomaly. Neutrophils have heart-shaped (inset A) and reniform-shaped (inset B) nuclei. Chromatin is mature and clumped in both cells. Modified Wright’s stain; 100× magnification
Prognosis & Outcome
There is no significant difference between dogs with and without Pelger-Huët anomaly concerning neutrophil adherence, movement, chemotaxis, phagocytosis, or bacterial killing.4 Moreover, there is no evidence of predisposition to infection or immunodeficiency in dogs with Pelger-Huët anomaly.4
Inherited Pelger-Huët anomaly is benign, but it is important to differentiate this condition from a left shift associated with inflammatory disease to avoid unnecessary treatment, further diagnostic testing, and associated medical expenses.5 Inherited Pelger-Huët anomaly should also be differentiated from pseudo-Pelger–Huët anomaly, which is a transient, acquired condition identified in multiple species (including cattle, horses, dogs, cats, and humans). In pseudo-Pelger–Huët anomaly, neutrophils have similar morphologic features, reflecting asynchronous maturation, that arise secondary to infections, myelodysplastic syndromes, or drug treatments.1,2 In humans, pseudo-Pelger–Huët anomaly has been associated with administration of many drugs (eg, sulfadiazine/trimethoprim, immunosuppressive agents, ibuprofen).5 It has also been identified in patients with coronavirus disease of 2019 (ie, COVID 19).9
Differentiation can be made via blood smear evaluation of the morphologic features of nuclear lobes, nuclear size, and chromatin pattern.5 In healthy patients with inherited Pelger-Huët anomaly, the granulocyte chromatin is more clumped than with pseudo-Pelger–Huët anomaly and there is no evidence of toxic change present in the neutrophils. Moreover, in contrast to the inherited form, in which all granulocytes are typically affected to some degree, not all (and often a minority) of the neutrophils are typically affected in pseudo-Pelger–Huët anomaly cases.6,10-12
If the patient’s parents and siblings are available for blood smear analysis, demonstration of similar granulocyte morphology may be helpful for a definitive diagnosis of inherited Pelger-Huët anomaly.4 To the authors’ knowledge, no genetic tests for inherited Pelger-Huët anomaly in veterinary species are available.
Take-Home Messages
Pelger-Huët anomaly is a benign, inherited, autosomal dominant condition found in dogs, cats, horses, rabbits, mice, and humans.2
Hyposegmentation of mature granulocytes (ie, neutrophils, eosinophils, basophils) that concurrently have mature, coarse chromatin is the defining feature of Pelger-Huët anomaly.1,2
Affected patients have no clinical signs of illness, as there is no disease, and have normal granulocyte function.4
High index of suspicion for this condition is warranted for healthy Australian shepherd dogs and other commonly affected breeds with a high number of band- and immature-appearing neutrophils that exhibit mature nuclear chromatin and no evidence of toxic change.3
Congenital Pelger-Huët anomaly should be differentiated from the acquired, transient form, which may arise secondary to infection, myelodysplastic disease, and administration of certain drugs.1,5
Identification of Pelger-Huët anomaly in affected patients is important to avoid unnecessary treatment, diagnostic testing, and further medical expense.5